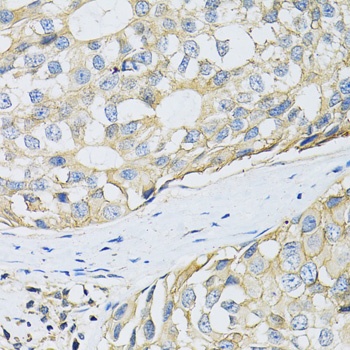
SLC3A2 Antibody
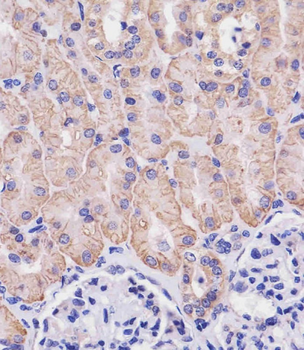
SLC3A2 Antibody (C-term)

You have no items in your shopping cart.
- SLC3A2 antibody [orb507590]Featured

ICC, IF, IHC-P, WB
Human, Mouse, Rat
Rabbit
Polyclonal
Unconjugated
100 μg - Featured

Human
0.16-10 ng/mL
0.063 ng/mL
96 T, 48 T - Human CD98 [orb2992764]
Unconjugated
SDS-PAGE: Greater than 90% as determined by reducing SDS-PAGE. (QC verified)
Predicted: 72.7 KDa. Observed: 75-120 KDa, reducing conditions
1 mg, 500 μg, 50 μg, 10 μg - Rhesus Macaque CD98 [orb2992918]
SDS-PAGE: Greater than 95% as determined by reducing SDS-PAGE. (QC verified)
Predicted: 47.7 KDa. Observed: 50-89 KDa, reducing conditions
1 mg, 500 μg, 50 μg, 10 μg - Mouse CD98 [orb2992676]
SDS-PAGE: Greater than 95% as determined by reducing SDS-PAGE. (QC verified)
Predicted: 48.5 KDa. Observed: 45-55 KDa, reducing conditions
1 mg, 500 μg, 50 μg, 10 μg - Biotinylated Human CD98 [orb2992890]
SDS-PAGE: Greater than 95% as determined by reducing SDS-PAGE. (QC verified)
Predicted: 49.5 KDa. Observed: 55-90 KDa, reducing conditions
100 μg, 20 μg - Human CD98 [orb2995007]
Unconjugated
SDS-PAGE: Greater than 95% as determined by reducing SDS-PAGE.
Predicted: 47.89 KDa. Observed: 57-87 KDa, reducing conditions
10 μg, 50 μg, 500 μg, 1 mg - Human CD98 [orb2993070]
Unconjugated
SDS-PAGE: Greater than 95% as determined by reducing SDS-PAGE.
Predicted: 47.7 KDa. Observed: 58-80 KDa, reducing conditions
10 μg, 50 μg, 500 μg, 1 mg